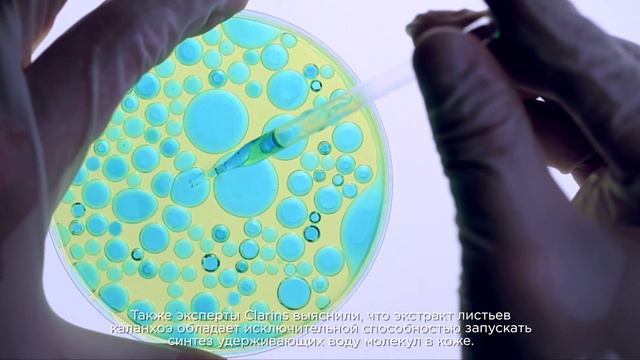
Каланхоэ: растение, которое не знает жажды смотреть онлайн

Автор: Nature Ninjas Страница 4

EXTREME DINING ROOM MAKEOVER! *APARTMENT EDITION! | Holiday Decor + DIY Wall Hanging!

Summer Ritual Box Walkthrough

Cherimoya Bonsai Dec 2019
Каланхоэ: растение, которое не знает жажды

PALM RESORT 2* Индия Север Гоа обзор – отель ПАЛМ РЕЗОРТ 2* Север Гоа видео обзор

Zygo Carecollab video of how I grow Zygopetalum orchids in my home, hope you enjoy it..

Инферно - Парень чернокожий feat. Левитан
![🐶 La razón de estar contigo - [A Dogs Purpose] Opinión de la 🎬 MOVIE 🎬 смотреть онлайн](https://pic.rutubelist.ru/video/a9/87/a98787874192fadd5d31fc973f7c9fad.jpg?size=m)
🐶 La razón de estar contigo - [A Dogs Purpose] Opinión de la 🎬 MOVIE 🎬

ЕГИПЕТ 2010 Palm Beach.mpg

Escape From Raffles Hotel At Dubai EightGames walkthrough..

The Retreat Palm Dubai

DERROTE O SKIBIDI TOILET REALISTA DO ROBLOX PARA EVOLUIR

7 Meses e batendo palma | 7 Months and clapping | Sofia Grace

The Witcher 3 ПРОХОЖДЕНИЕ № 39 ЗАДАНИЕ ДА ЗДРАСТВУЕТ ИСКУССТВО

Я пою в месте с джуди

Катерина Семёнова Ночная прогулка Дмитрий Прянов

ФОРТНАЙТ! ЛЕЙТЫ С ПОДПИСЧИКАМИ + АРЕНА!

Bleach blonde silver mauve

Almond tree & Lavender fields in Provence harvest season Part 2

Играй баян Сиреневый туман

САЛЮ ОГОРОД ПО ЗАКАЗУ ЗРИТЕЛЕЙ

Ask the Garden Gal: Butterfly Bush

Lemongrass & Lavender

Nhato - Curiosity // In the Usual Motion
За каждым успешным каналом стоит личность, идея и сотни часов кропотливого труда. Если вы здесь, значит, автор «Nature Ninjas» уже сумел зацепить ваше внимание своим уникальным стилем или подачей. А мы на RUVIDEO позаботились о том, чтобы вы могли изучить весь архив его работ в максимально комфортных условиях — без лишней суеты и преград.
Почему за работами канала «Nature Ninjas» так интересно наблюдать? Всё просто: это честный контент, который находит отклик в сердцах зрителей. На нашем ресурсе вы можете смотреть онлайн все видео любимого автора бесплатно и в хорошем качестве. Нам важно, чтобы вы видели каждую деталь и слышали каждый нюанс, поэтому мы используем только стабильные плееры из открытых источников Rutube.
Следите за новинками канала, пересматривайте старые шедевры и открывайте для себя новые грани творчества «Nature Ninjas». Мы постоянно обновляем ленту, чтобы у вас под рукой всегда были самые свежие выпуски. Никаких сложных регистраций — только вы и творчество, которое вдохновляет. Приятного вам путешествия по миру авторского контента на RUVIDEO!
Видео взято из открытых источников Rutube. Если вы правообладатель, обратитесь к первоисточнику.